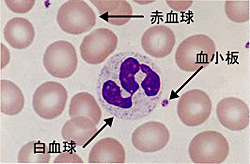

検体検査室
検体検査室のご案内
生化学検査とは?
生化学検査は、人の体液(血液、胸水、腹水など)を使って病状を検査します。
主に血液中に含まれる酵素や糖質、蛋白質などを調べ、各臓器の状態を調べます。
例としては・・・
| AST(GOT)、ALT(GPT)、γ-GTP、ビリルビン | 肝臓の障害 |
| LD、CK、CK-MB、トロポニンI 、BNP | 心筋梗塞、心不全 |
| 総コレステロール、中性脂肪、HDLコレステロール、LDLコレステロール | 動脈硬化 |
| 総アミラーゼ、膵型アミラーゼ | 膵炎 |
| 尿酸 | 痛風 |
| 尿素窒素(BUN)、クレアチニン | 腎臓の障害 |
| Na、K、Cl、Ca、P、Mg | 電解質代謝異常 |
| 血糖、ヘモグロビンA1C | 糖尿病 |
| CRP、PCT | 炎症、細菌感染 |
| 鉄、UIBC、フェリチン | 鉄欠乏性貧血 |
免疫血清検査とは?
免疫血清検査は、主に血液の中にウイルスや細菌に対する抗体が存在するか、またウイルス自身が存在するか調べます。その他に腫瘍マーカーや血中薬物濃度の測定なども行っています。
例としては・・・
| HBs抗原、HBs抗体、HBc抗体、HCV抗体、HIV抗原/抗体 | B型肝炎、C型肝炎、HIV感染症 |
| RPR、TPLA | 梅毒 |
| CA19-9、CEA、PSA、AFP、CA125、CA15-3 | 癌腫瘍マーカー |
| IgG、IgA、IgM | 免疫グロブリンの異常 |
| IgE | アレルギー |
| RF | リウマチ |
| TSH、フリーT3、フリーT4 | 甲状腺 |
これはあくまでも例であって、「検査で血糖値が高かったから、私は糖尿病だ」ということにはなりません。これらの検査データはレントゲン、問診での患者さんの答えといった多くの情報をもとに、総合して医師が判断するのです。生化学および免疫血清検査のいずれにしても心電図などの生理検査とは異なり、直接患者さんに接することはありませんが、正確なデータをより早く届けることでスムーズな診療に貢献したいと考えています。
血液検査とは?
血液検査は主に、赤血球・白血球・血小板に関する検査です。数や割合、働きを検査することによって、様々な血液の病気や体の状態を知ることが出来ます。
例えば、
・赤血球の異常:貧血(鉄欠乏性貧血など)
・白血球の異常:感染症(ウイルス,細菌),炎症,白血病
・血小板の異常:出血傾向(血が止まりにくい)
血液に関する様々な検査
それぞれの異常を見逃さないために、次のような検査を行っています。
- 血球の数や貧血の指標となるヘモグロビン濃度などを測る血球算定検査
- 働きによって主に5つに分類される白血球(好中球,リンパ球,単球,好酸球,好塩基球)の割合や血球形態の異常を顕微鏡で調べる血液像検査
- 血管の損傷などで出血した場合に、どの程度体の中で止血の働きをしているか調べる凝固検査(プロトロンビン時間APTTなど)
- 経口抗凝血薬(ワ-ファリン)療法のコントロールとなるPT-INR
- 抗血小板療法の指標として、血小板の働きを調べる血小板凝集能検査
- 骨髄で造られる若い血球(赤血球や白血球などのもとになる細胞)の数や割合、血球形態を顕微鏡で観察し、白血病などの血液疾患をみる骨髄像検査
- 細胞1個1個を染色、レーザーを照射し、白血球の種類を同定するフローサイトメトリー
その他にも血液に関する様々な検査を行っています。
血液の疾患は貧血から白血病まで様々あります。血液そのものの異常は通常の生活に支障をきたす場合もあります。それだけにより早く異常を見つけ出し、適切な処置を行えるように検査をしています。
一般検査とは?
一般検査は主に尿を検査します。他に便や腹水、胸水、髄液、関節液なども検査します。
尿は採血と違い比較的採取が容易です。その上、尿には多種多様な物質が含まれており、鋭敏に体の変化を反映します。そのため、腎臓や尿路系の異常以外にも様々な疾患の診断に欠かせません。
尿検査としては尿定性と尿沈渣を主に行っています。どんな検査かというと・・・
尿定性検査
健康診断などで「尿潜血(2+)」とか「尿蛋白(+)」など聞いたことがありませんか?
検査室では他に糖やビリルビンなど合わせて10種類の項目を、試験紙を使って化学的に検査しています。どの項目がどの程度陽性なのかによって体の状態を知り、様々な疾患を探ることが出来ます。

尿沈渣
尿中に出てきた細胞や固形成分を顕微鏡で観察します。普通では尿には出てこないものや、異常に数が増えているものなどを見つけ出します。尿沈渣は発病期に異常を示す場合が多く、しかも急激に変化するため、初めに尿沈渣で異常が見つかる事もあります。
尿検査で異常がある場合にはさらに詳しい検査を行い、総合的に判断することになります。つまり尿検査=スクリーニング検査といえます。
便検査として便潜血検査があります。大腸がんの検診で検査をすることからも分かるように、下部消化管出血の有無を知り、病気が隠されていないかを調べます。
尿や便などは色や量の異常を自分でチェックし、毎日の健康管理に役立つことが出来ます。それだけ身近なものであり、体の様々な情報を教えてくれるとても大事なものなのです。
